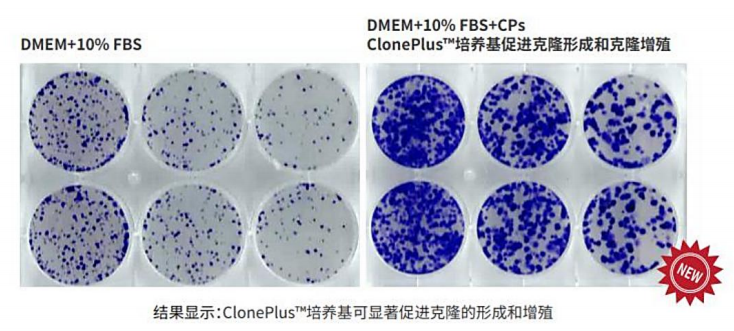

抗体广泛存在于生物医学研究、 诊断和治疗的发展中, 且需求量大。然而, 满足全球市场日益增长的抗体需求量是一个巨大的挑战。为了维持抗体的供求平衡, 科学家们发明了更好的方法来优化抗体的表达, 以达到增加抗体的单体积表达量并减少生产成本。由于新的克隆方法、基因改造技术以及一系列的细胞和载体工程技术, 加上发酵技术上的改进, 这些都使抗体表达大大得益。
哺乳动物细胞是临床抗体药物产品使用的主要表达系统, 主要包括Sp2/0骨髓瘤细胞、 NS0小鼠骨髓瘤细胞、 HEK293人胚胎肾细胞和CHO中国仓鼠细胞, 其中以CHO系应用最为广泛。
| 基于CHO细胞的抗体表达系统简介

细胞株开发常用的CHO细胞:DG44, DUXB11, CHO-S, CHO-K1 WT, CHO-K1 GS-/-
筛选标记 | 筛选试剂 | |
代谢型筛选标记 | 二氢叶酸还原酶(DHFR) | 甲氨蝶呤 (MTX) |
谷氨酰胺合成酶(GS) | 氨基亚砜蛋氨酸 (MSX) | |
抗生素筛选标记 | 嘌呤霉素搞性(Puromycin acetyltransferase) | 嘌呤霉素 (Puromycin) |
杀稻瘟脱氢酶(Blasticidin deaminase) | 杀稻瘟霉素 (Blasticidin) | |
组氨醇脱氢酶(Histidinol dehydrogenase) | 组氨醇 (Histidinol) | |
潮霉素磷酸转移酶(Hygromycin phosphotransferase) | 潮霉素 (Hygromycin) | |
氯林可霉素而药基因(Zeocin resistance gene) | 氯林可霉素 (Zeocin) | |
博来霉素耐药基因(Bleomycin resistance gene) | 博来霉素 (Bleomycin) | |
氨基糖苷磷酸转移酶(Aminoglycoside phosphotransferase) | 新霉素 (Neomycin or G418) |
CHO细胞的优点
1. CHO细胞遗传背景清晰, 不易传播人类病毒, 具有很高的安全性, 以CHO作为宿主细胞表达生物蛋白质, 容易被药物审核机构, 如FDA审批通过
2. CHO细胞可以通过悬浮驯化适应无血清悬浮培养, 并能够实现在无血清培养基中快速及高密度生长,这为药物的质量控制和大规模生产带来极大的便利和实惠;
3. CHO细胞表达的重组蛋白质能够获得类似于人源蛋白质的翻译后修饰, 如翻译后的糖基化修饰、 唾液酸化修饰等, 生产的蛋白质较其它表达系统更加与人体天然的生物蛋白质相似第四, 较少分泌内源性蛋白, 降低纯化难度;
4. CHO细胞已经开发出了多种商业化高效高表达系统, 如二氢叶酸还原酶筛选体系、 谷氨酰胺合成酶筛选体系和遗传霉素筛选体系等。
CHO细胞的异质性特征
CHO细胞在长期传代过程中存在的稳定性表达问题, 主要体现在:
1. CHO 细胞遗传不稳定性引起的表达不稳定
CHO 细胞系基因组本身具有不稳定性。通常, 中国仓鼠体细胞的染色体为 11 对22 条, 而中国仓鼠卵巢细胞的染色体则发生了大面积不稳定重排重组现象, 不同细胞系染色体的数目也不恒定。基因组的不稳定性, 主要表现在其染色体层面上的拷贝数变异。
2. 外源基因随机整合引起的表达不稳定
传统方法主要是通过表达质粒转染后, 利用压力筛选从而获得目的蛋白质表达细胞株。因此, 外源基因都是通过随机整合方式, 整合到CHO 基因组内。由于整合位点的不确定性, 可能在细胞培养后期引起表达不稳定。

中国仓鼠卵巢细胞拥有22 条染色体, 其中10 对常染色体及2 条性染色体。而CHO-K1 细胞系则显示出与其有极大的不同,其仅有8 条染色体显示出同普通中国仓鼠染色体相同, 而13个染色体则以“Z” 标志, 因其中包含着染色体重排、 缺失、移位等现象。
| 抗体表达CHO细胞株的构建策略与流程
1. 细胞内的蛋白表达过程
转录 → mRNA加工 → 翻译 → 翻译后折叠与修饰 → 细胞内转运 → 分泌

2. 抗体表达CHO细胞株的构建策略

Representation of different steps involved in building an efficient system for protein expression
3. 重组蛋白表达工程细胞株的构建流程图
载体构建 → 转染 → 细胞池(pool) 筛选 → 单克隆化筛选 → 批次补料培养筛选 → 蛋白质量筛选 → 细胞株最终选定与建库 → 细胞培养工艺开发与生产

(1)重组抗体表达载体构建:载体元件改造, 密码子优化, 信号肽优化等
(2)影响细胞转染环节的因素:转染效率和细胞活性
(3)单克隆筛选:有限稀释法、ClonePix、FACS
细胞的克隆形成是一个缓慢而且效率很低的技术过程,但是很多细胞实验都需要经过一个单克隆生长阶段,为了增加细胞株的克隆形成的效率,我们研发了该款细胞培养基。ClonePlusTM培养基含有多种细胞培养添加成分,包括:

我们还能为您提供:
客户成果
客户成果

案例分析
案例分析
参考文献
参考文献